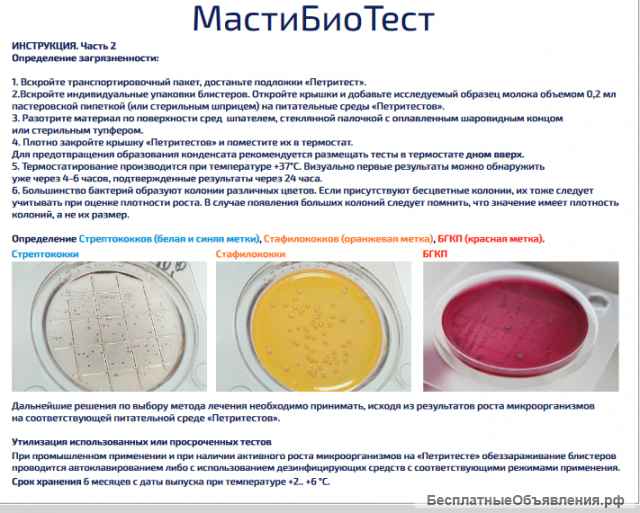

Экспресс тест для определения патогенных микроорганизмов в молоке
А) Набор «МастиБиоТест» содержит в себе:
1. Набор «Петритестов» с тремя оригинальными средами для определения стрептококка (Streptococcus spp.),
стафилококка (Staphylococcus aureus), бактерий группы кишечной палочки (БГКП).
Каждый «Петритест» позволяет культивировать только одну группу микроорганизмов, вызывающих мастит.
2. Стерильную одноразовую пробирку.
3. Одноразовые дезинфицирующие салфетки для сосков.
4. Стерильный инструмент для посева образца на «Петритест».
Б) Отбор проб молока для посева на «Петритест» и культивирования микроорганизмов:
1. Перед взятием пробы вымя и соски необходимо тщательно вымыть от грязи, остатков навоза и т.д.
2. Из каждого соска 8 раз выдоить струёй в отдельную тару.
3. Конец каждого соска продезинфицировать одноразовой салфеткой.
4. Взять пробу молока в прилагаемый стерильный контейнер (пробирку).
Пробу можно взять из больной части вымени, или из всех сосков сразу.
Утилизация использованных или просроченных тестов
При промышленном применении и при наличии активного роста микроорганизмов на «Петритесте» обеззараживание блистеров
проводится автоклавированием либо с использованием дезинфицирующих средств с соответствующими режимами применения.
Срок хранения 6 месяцев с даты выпуска при температуре +2.. +6 °С.
Стрептококки Стафилококки БГКП
Дальнейшие решения по выбору метода лечения необходимо принимать, исходя из результатов роста микроорганизмов
на соответствующей питательной среде «Петритестов».
НПО
Готовый экспресс-тест для с тремя оригинальными средами на определение стрептококка (Streptococcus spp.), стафилококка (Staphylococcus aureus), бактерий группы кишечной палочки (БГКП). Каждый «Петритест» позволяет идентифицировать рост только одной группы бактерий, вызывающих мастит у крупного и мелкого рогатого скота.
- Соответствуют требованиям действующего санитарного законодательства РФ
- Возможность визуализировать колонии по цвету.
- Удобство подсчета колоний.
- Соответствует классическим методам исследований.
- Результаты через 24 часа.
1. Набор «Петритестов» с тремя оригинальными средами для определения стрептококка (Streptococcus spp.),
стафилококка (Staphylococcus aureus), бактерий группы кишечной палочки (БГКП).
Каждый «Петритест» позволяет культивировать только одну группу микроорганизмов, вызывающих мастит.
2. Стерильную одноразовую пробирку.
3. Одноразовые дезинфицирующие салфетки для сосков.
4. Стерильный инструмент для посева образца на «Петритест».
Б) Отбор проб молока для посева на «Петритест» и культивирования микроорганизмов:
1. Перед взятием пробы вымя и соски необходимо тщательно вымыть от грязи, остатков навоза и т.д.
2. Из каждого соска 8 раз выдоить струёй в отдельную тару.
3. Конец каждого соска продезинфицировать одноразовой салфеткой.
4. Взять пробу молока в прилагаемый стерильный контейнер (пробирку).
Пробу можно взять из больной части вымени, или из всех сосков сразу.
Утилизация использованных или просроченных тестов
При промышленном применении и при наличии активного роста микроорганизмов на «Петритесте» обеззараживание блистеров
проводится автоклавированием либо с использованием дезинфицирующих средств с соответствующими режимами применения.
Срок хранения 6 месяцев с даты выпуска при температуре +2.. +6 °С.
Стрептококки Стафилококки БГКП
Дальнейшие решения по выбору метода лечения необходимо принимать, исходя из результатов роста микроорганизмов
на соответствующей питательной среде «Петритестов».
НПО
Готовый экспресс-тест для с тремя оригинальными средами на определение стрептококка (Streptococcus spp.), стафилококка (Staphylococcus aureus), бактерий группы кишечной палочки (БГКП). Каждый «Петритест» позволяет идентифицировать рост только одной группы бактерий, вызывающих мастит у крупного и мелкого рогатого скота.
- Соответствуют требованиям действующего санитарного законодательства РФ
- Возможность визуализировать колонии по цвету.
- Удобство подсчета колоний.
- Соответствует классическим методам исследований.
- Результаты через 24 часа.
| Цена: |
850 руб
|
| Город: |
Саратов
|
| Тип: | Продаю |
| Автор: |
|
На сайте с 05.04.2023 
|
|
| Сайт: | petritest.ru/petritest-smyv |
| Дата: | 10.04.2023 22:51 |
| Номер: | 2581810 |
Сделать объявление:
Ссылка на это объявление:
Похожие объявления

Газорегуляторные пункты ГРПШ, ШГРП, ШРП, ПРДГ, ГРПБ, ПГБ, ГСГО, ГРПН, ГРП, УГРШ
136 000 руб
24.11.2025

Фильтрация масел
100 руб
Вчера

Купим радиоприборы СССР: Осциллографы, частотомеры, вольтметры, самописцы, генераторы сигн, платы
Без цены
17.11.2025

Выездная очистка масел
Без цены
Вчера

Газорегуляторные пункты ГРПШ-13-2НУ1, ГРПШ-13-2ВУ1, УГРШ-50Н, УГРШ-50В, ГСГО-50
212 000 руб
24.11.2025

Шар 20,638 гост 3722-81 шх15
18 руб
Сегодня 07:08

Куплю радиодетали приборы ссср
Без цены
27.02.2024

Опоры трубопроводов
500 руб
24.12.2024

Подшипник 1314 CRAFT
1 200 руб
Сегодня 07:08

Шарнирная головка SI08T/K
150 руб
Сегодня 07:07

Корпус подшипника в сборе UCP203
350 руб
Сегодня 07:08

Земснаряд Ахтарец 1400 / 40 дизельный, гидро. ЗМК
33 300 000 руб
02.11.2025

Пункты учета газа ПУРГ, ШУУРГ, БУУРГ, УУРГ, УУГ
160 000 руб
24.11.2025

Куплю радиостанции и радиоприёмники СССР: Виола, Ангара, Днепр, Р-159, Р-107м, Р-250, Р-155, Р399А
Без цены
17.11.2025

Производство электротехнического оборудования
Без цены
15.09.2025

Шарнирная головка SI10 T/K
210 руб
Сегодня 07:07

Купим дорого радиодетали СССР: Конденсаторы, микросхемы, транзисторы, реле, переключатели, платы
Без цены
17.11.2025

Подшипник F-16201 FERSA
1 200 руб
Сегодня 07:07

Подшипник 7226-B-MP-UA производства FAG
15 000 руб
Сегодня 07:08

Газорегуляторные пункты блочные ПГБ-13-2НУ1, ПГБ-13-2ВУ1, ПГБ-50
610 000 руб
24.11.2025

Круглый корпус подшипника в сборе UCFC204 вал 20 мм
420 руб
Сегодня 07:07

Система Домашней Автоматизации TELETASK (Умный Дом)
250 000 руб
11.09.2025

Газорегуляторные пункты ГРПШ-04-2У1, ГРПШ-05-2У1, ГРПШ-07-2У1, ГРПН-300-01
136 000 руб
24.11.2025

Экспресс тест на Синегнойную палочку (петритест)
1 900 руб
11.04.2023

Фильтроэлементы очистки тонкой и грубой масла и топлива
100 руб
21.05.2025

Газорегуляторные пункты блочные ПГБ-02-2У1, ПГБ-04-2У1, ПГБ-05-2У1, ПГБ-07-2У1
490 000 руб
24.11.2025

Навигационное оборудование. Саратов
1 650 000 руб
28.07.2023

Промышленные дымоходы. Дымовые трубы.
35 000 руб
11.09.2025

Ролик крыши 55.3367
320 руб
Сегодня 07:07

Шарнирный наконечник SI10T/K внутренняя резьба
220 руб
Сегодня 07:08

Газорегуляторные пункты в шкафном и блочном исполнении ГРПШ, ШГРП, ШРП, ПРДГ, ГРПБ, ПГБ, ГСГО, ГРПН, ГРП, УГРШ предназначены для редуцирован...